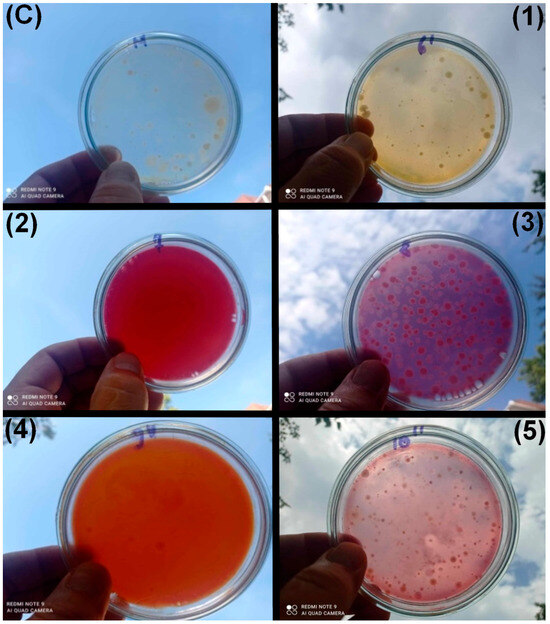

Abstract
In this paper, a toxicological investigation was carried out on a series of azoic direct dyes generally with an affinity for cellulosic fibers, presenting symmetrical and asymmetrical structures having as a central component a non-carcinogenic, mutagenic, or teratogenic and accessible precursor potential substitute for benzidine, namely 4,4′-diaminobenzanilide, and, as coupling components, 2-hydroxybenzoic acid, 2-hydroxy-3,6-naphthalenesulfonic acid, 2-amino-8-hydroxynaphthalene-6-sulfonic acid, 1-amino-8-hydroxynaphthalene-3,6-disulfonic acid, 1-(4′-sulfophenyl)-3-methyl-5-pyrazolone, and 2-hydroxy-6-naphthalenesulfonic acid, respectively. For the purpose of their safe use, this study shows the results regarding the toxicity of the above-mentioned dyes, obtained through biological tests on colonies of Hydractinia echinata (H. echinata). The toxicity tests were performed on heterotrophic bacteria cultures obtained from the Bega River. The minimum toxic concentration was monitored using the dilutions 0.6 g/L, 24 g/L, and 48 g/L, obtained by dilution of a stock solution of 60 g/L. The symmetric dye with the coupling component 2-hydroxybenzoic acid presents the highest degree of toxicity, the lowest being shown by dyes with symmetric and asymmetric structures with the following coupling components: 2-amino-8-hydroxynaphthalene-6-sulfonic acid, 1-amino-8-hydroxynaphthalene-3,6-disulfonic acid, 1-(4′-sulfophenyl)-3-methyl-5-pyrazolone, and 2-hydroxy-6-naphthalenesulfonic acid.
1. Introduction
Azo dyes are colored organic compounds that contain in the molecule one or more azo groups (N=N), through which different aromatic residues are linked; the number of possible derivatives is practically unlimited, they are obtained relatively easy, and their color varies with the nature, position, and number of substituents in the molecule. The above-mentioned class compounds cover the entire range of possible colors and shades with the most varied tinctorial properties and resistance to the action of external physical and chemical agents [1].
Apart from coloring textile fibers [2], organic azo dyes serve for many other purposes, among which the most important are coloring leather, paper, plastic, printing inks [3,4], and food [5], etc. According to the physico-chemical properties on the one hand, and to the biological activity on the other, the applications of azo dyes extend in many domains: pharmacological [6], biological [7], high-tech applications such as being sensitized to solar cells [8], and medicine [9,10], etc.
It is well known that the azo bond (N=N) in the dyes under discussion presents a reduced stability; therefore, one of the ways they degrade is through the reduction and the release of the corresponding aromatic amines. Photo-degradation [11] and biodegradation [12] are other possible variants. The toxicity of azo dyes [13,14] is associated with the toxicity of the intermediates used to obtain them. In this regard, the international organizations IARC (International Agency of Research on Cancer) and ETAD (Ecological and Toxicological Association of the Dyestuffs Manufacturing) have published lists containing amines with carcinogenic, mutagenic, or teratogenic characteristics [15,16].
The well-known benzidine dyes were retired from the circuit in time; therefore, significant efforts were made to replace benzidine with alternative amines to be used as intermediates in the acquirement of dyes. The aim was to obtain alternative dyes with coloristic and fastness properties close to the benzidine one. The attempts to replace benzidine were schematized in two research directions, namely one which implies the use of homologues of benzidine [17] and the other which requires non-homologues of benzidine compounds [18,19].
In this regard, over time, the research in this domain shows that 4,4′-diaminobenzanilide represents a non-carcinogenic, mutagenic, or teratogenic and accessible precursor [20]. This type of intermediate can be bis-diazotized and coupled with various coupling components in order to obtain symmetrical or asymmetrical dis-azo, tris-azo, and tetrakis-azo dyes. These dyes in the above-mentioned class (namely, direct dyes) can cover the entire range of shades, generally having an affinity for cellulosic materials, similar to those from the benzidine one. Their coloristic and fastness properties after the dyeing process were compared as expected with those of the benzidine analogues, with the results being up to standard [21,22,23,24,25,26,27,28,29,30].
The persistence of aromatic amines and their related dyes in most organic effluents encourage the need of the development of new approaches in evaluating of their toxicity. The in vitro and in vivo experiments on animals as toxicity tests present a number of disadvantages such as the concern of the subjects and an expensive and spread out work. In this regard, the improvement of a method for the toxicity evaluation based on biological tests proved necessary. A practical and attractive alternative can be considered, which is the method applied on colonies of Hydractinia echinata (H. echinata). The scientific literature supplies data regarding the toxicity evaluation based on this method on a wide range of compounds [31,32]. This approach of the structure–toxicity relationship study of dyes generally and of azoic direct dyes particularly, as those derived from the above-mentioned eco-friendly precursor, namely 4,4′-diaminobenzanilide, were developed using Hydractinia echinata (H. echinata) and were unsatisfactorily presented [23,25].
The release of new products on the industrial market is increasingly facing the problem of environmental pollution at the present time. Before using these new products on a large industrial scale, they must be studied from the point of view of their toxicity on environmental organisms. It is very important to study the toxic effect of these compounds on the microorganisms in the environment because they have an essential role in the environment. Because of their widespread presence and diverse metabolic capacities, microbes are impacted by pollution, which has an impact on both the host organisms and the way their surroundings operate [33].
By breaking down, modifying, and transferring organic or inorganic substances, they also have a significant impact on the fate of contaminants. Therefore, they are essential for the creation of biological solutions for the environmental hazard assessment of chemicals and nature-based solutions for pollution reduction.
Taking into account all these aspects, our study aims to evaluate the toxicity of a new range of dyes intended for industry by establishing their minimum toxic concentration on heterotrophic microorganisms in the environment. The minimum toxic concentration of a compound on an organism or group of organisms represents the concentration at which that compound becomes toxic. Thus, at this concentration, the compound has measurable effects on the target organism manifested at the level of metabolism, growth, and development, etc. [34]. Determining the minimum toxic concentration is important, especially for new synthetic products because, depending on this, the maximum concentration allowed in the environment will be established.
2. Materials and Methods
2.1. Synthesis of the Dyes
In the first step, 4,4′-diaminobenzanilide was bis-diazotised by the direct method in concentrated mineral acid medium with sodium nitrite. In the second step, in order to obtain the dyes with symmetrical and asymmetrical structures shown in Scheme 1, the bis-diazoniu salt of the central component, 4,4′-diaminobenzanilide, was treated with the corresponding coupling components, namely 2-hydroxybenzoic acid for dye Ia, 2-hydroxy-3,6-naphtalenesulphonic acid for dye Ib, 2-amino-8-hydroxynaphtalene-6-sulphonic acid and 1-amino-8-hydroxynaphtalene-3,6-disulphonic acid for dye Ic, 2-hydroxybenzoic acid and 1-(4′-sulfophenyl)-3-methyl-5-pirazolone for dye Id, and 2-hydroxy-6-naphtalenesulphonic acid for dye Ie, respectively, at a temperature around 8 °C. The pH value was chosen according to the nature of the coupling component. These are as follows: pH = 8.5–9 for dye Ia, pH = 8.5–9 for dye Ib and Ie, pH = 3.5–4/8–9 for dye Ic, pH = 7–8/9 for dye Id. Detailed information about the materials and methods used in the synthesis of the dyes in question can be found in previously published articles [23,25,26].


Scheme 1.
Chemical structures of the dis-azo dyes Ia–Ie.
2.2. Toxicity of the Dyes
To determine the toxicity of dyes on microorganisms in the environment, this study determined their minimum toxic concentration. For this, increasing dilutions of the dyes were used: 0.6 g/L, 1.2 g/L, 24 g/L, and 48 g/L, obtained by diluting a 60 g/L stock solution. The toxicity tests were performed on heterotrophic bacteria cultures obtained from the Bega River. Bacteria cultures were obtained on a solid non-selective growth medium—Plate Count Agar, making two types of test cultures (3 repeats)—using test solutions with dye solution and control cultures without dye test solution.
Inoculation method was performed via incorporation into Plate Count Agar growth medium, in sterile Petri dishes, which were incubated at 35 °C for 48 h. For test cultures, in sterile Petri dishes, 1 mL of test solution, 1 mL of bacterial inoculum, and 10 mL of Plate Count Agar growth medium were introduced. In control cultures, instead of the test solution, 1 mL of sterile distilled water was used [35,36].
3. Results and Discussion
3.1. Synthesis of the Dyes
The synthesis of the symmetrical dyes Ia, Ib, and Ie with structures shown in Scheme 1 involved the bis-diazotization of 4,4′-diaminobenzanilide and the coupling reactions of the resultant bis-diazoniu salt with 2-hydroxybenzoic acid, 2-hydroxy-3,6-naphtalenesulphonic, and 2-hydroxy-6-naphtalenesulphonic acid, respectively, as coupling components. Regarding the synthesis of the asymmetrical dyes with structures also depicted in Scheme 1, these involved the bis-diazotization of 4,4′-diaminobenzanilide and the coupling reactions of the resultant bis-diazoniu salt with 2-amino-8-hydroxynaphtalene-6-sulphonic acid, 1-amino-8-hydroxynaphtalene-3,6-disulphonic acid for dye Ic, and 2-hydroxybenzoic acid and for dye Id, respectively. More details can be found in the literature [23,25,26].
3.2. Toxicity of the Dyes
After testing with increasing concentrations of dye and comparing them with a control (C) without dye, the following were found: for dye Ia, the minimum toxic dose was 1.2 g/L (Figure 1); for dye Ib, this was 24 g/L (Figure 2); and for dyes Ic, Id, and Ie, this was 48 g/L (Figure 3, Figure 4 and Figure 5). In this regard, the results of the toxicity of dyes Ia–Ie are given in Figure 1, Figure 2, Figure 3, Figure 4 and Figure 5. The pictures of toxicity tests of dyes found in the culture medium in different moments of the study are shown in Figure 6.

Figure 1.
Bacterial growth after 48 h in the presence of dye Ia compared to the control without dye (CFU = Colony-Forming Unit).

Figure 2.
Bacterial growth after 48 h in the presence of dye Ib compared to the control without dye (CFU = Colony-Forming Unit).

Figure 3.
Bacterial growth after 48 h in the presence of dye Ic compared to the control without dye (CFU = Colony-Forming Unit).

Figure 4.
Bacterial growth after 48 h in the presence of dye Id compared to the control without dye (CFU = Colony-Forming Unit).

Figure 5.
Bacterial growth after 48 h in the presence of dye Ie compared to the control without dye (CFU = Colony-Forming Unit).
Figure 6.
Pictures of toxicity tests: (C) control; (1) dye Ia 0.6 g/L; (2) dye Ib 24 g/L; (3) dye Ic 48 g/L; (4) dye Id 48 g/L; (5) dye Ie 48 g/L.
As mentioned above, the dyes Ia–Ie studied in this paper were synthesized with the aim of replacing as much of the benzidine-based dyes as possible. Therefore, 4,4′-diaminobenzanilide was used, which represents a suitable precursor in the synthesis of the azo dyes as a central component. Under these conditions, it can be seen that the specified dyes do not show carcinogenic, mutagenic, or teratogenic characteristics [20,21,22,23,24,25,26,27].
Regarding the Ia, Ib, and Ie dyes’ toxicity, which implies the use of colonies of Hydractinia echinata (H. echinata), it was found from the values of the logarithm of the reciprocal value of the metamorphosis reducing concentration, log 1/MRC50, that they may be ecological products [23,25].
At the same time, the dye Id may be used in the textile industry; from a dermatologic point of view, this is the conclusion drawn on account of the results obtained by the in vivo imagistic skin evaluation [26].
This article describes several new dyes and their toxicity tests on environmental bacteria. It can be easily observed in Scheme 1 that dyes Ia–Ie with symmetrical and asymmetrical structures present the same diazotization component, namely 4,4′-diaminobenzanilide, and different coupling components. Therefore, it can be concluded that the toxic behavior of the studied dyes can be attributed to their different structures, as shown in Figure 1, Figure 2, Figure 3, Figure 4 and Figure 5.
The values for the minimum toxic dose, namely 1.2 g/L, obtained for dye Ia shown in Figure 1 indicate the association of its structure with the highest degree of toxicity. The data in the literature support the use of 2-hydroxybenzoic acid (salicylic acid) as a coupling component in the synthesis of benzidine-based direct dyes such as C.I. Direct Brown 2 (C.I. 22.311); C.I. Direct Brown 6 (C.I. 30.140); and C.I. Direct Brown 95 (C.I. 30.145) with good dyeing properties for textile fibers and leather [13].
2-Hydroxy-3,6-naphthalenesulfonic acid is not directly involved as a coupling component in the synthesis of benzidine-based dyes, but it plays a role in the production of other dyes, particularly sulfur dyes. From Figure 2, a drastic increase in the minimum toxic dose value, namely 24 g/L related to the study conducted on dye Ib, is observed.
Despite their different structures, due to different coupling components, the dyes Ic, Id, and Ie exhibit, as shown in Figure 3, Figure 4 and Figure 5, i.e., 48 g/L, the highest value of the minimum toxic dose, which indicates that, among the series of analyzed dyes, they have the lowest toxic characteristics.
The dye Ic, described in Scheme 1, with an asymmetric structure, has, as coupling components, 2-amino-8-hydroxynaphtalene-6-sulphonic acid and 1-amino-8hydroxynaphtalene-3,6-disulphonic acid. The above-mentioned intermediates were also used in the synthesis of benzidine dyes and used in fabric dyeing and paper coloring, for example, C.I. Direct Blue 6 (C.I. 22.610); C.I. Direct Blue 64 (C.I. 22.595); and Chlorazol RH [13,14].
1-(4′-sulfophenyl)-3-methyl-5-pirazolone, the coupling component of dye Id depicted in Scheme 1, and, obviously, its derivatives, are principally used for acid and reactive dyes such as Acid Yellow11 (C.I.188.20), with applications in cosmetics and medicine. With respect to benzidine dyes, Orange Direct 31 (C.I. 23.655) is involved in cellulose dyeing, as expected [13].
Regarding dye Ie, its coupling component, 2-hydroxy-6-naphtalenesulphonic acid, is related to the production of azo dyes, namely Acid Orange12 (C.I. 15.970) for biological dyeing, and Food Yellow 3 (C.I. 15.985) and Food Yellow 2 (C.I. 15.980) in the food industry.
Therefore, it can be observed that dye Ia exhibits the highest degree of toxicity, and dyes Ic, Id, and Ie show the lowest. It is also noted that dye Ib presents an intermediate level of toxicity.
It is not possible to establish a clear connection between toxicity and the symmetrical or asymmetrical structures of the dyes, but their potential toxicity, however, is closely linked to their chemical structure and the specific substituents present. The key factors that determine toxicity are the dyes’ stability, biodegradability, and the toxicity of their degradation products, rather than their symmetry.
As noticed, the results obtained regarding the toxicity of the studied series of dyes can be, in some measure, related to those of azo dyes in general and benzidine-based dyes in particular.
4. Conclusions
This article presents a toxicological assessment of a series of azoic direct dyes known for their affinity toward cellulosic fibers and featuring both symmetrical and asymmetrical molecular structures. The central component of these dyes is 4,4′-diaminobenzanilide, an accessible, non-carcinogenic, non-mutagenic, and non-teratogenic alternative to benzidine. The dyes were synthesized using various coupling agents, including 2-hydroxybenzoic acid, 2-hydroxy-3,6-naphthalenesulfonic acid, 2-amino-8-hydroxynaphthalene-6-sulfonic acid, 1-amino-8-hydroxynaphthalene-3,6-disulfonic acid, 1-(4′-sulfophenyl)-3-methyl-5-pyrazolone, and 2-hydroxy-6-naphthalenesulfonic acid.
Toxicity tests were conducted on heterotrophic bacterial cultures sourced from the Bega River. To determine the minimum toxic concentration, the following dilutions were tested: 0.6 g/L, 1.2 g/L, 24 g/L, and 48 g/L, prepared from a stock solution of 60 g/L.
Among the dyes studied, the symmetric compound using 2-hydroxybenzoic acid as the coupling component exhibited the highest level of toxicity. In contrast, dyes—both symmetric and asymmetric—containing the following coupling agents showed the lowest toxicity: 2-amino-8-hydroxynaphthalene-6-sulfonic acid, 1-amino-8-hydroxynaphthalene-3,6-disulfonic acid, 1-(4′-sulfophenyl)-3-methyl-5-pyrazolone, and 2-hydroxy-6-naphthalenesulfonic acid.
Even if one of the tested dyes (Ia) has a more pronounced toxicity, for the rest of the dyes, the toxicity manifested is moderate and weak. Considering the fact that, from industry, these dyes end up in diluted effluents at concentrations below the minimum toxic concentration determined by us in this study, we conclude that their industrial use is safe from the point of view of the effect on heterotrophic microorganisms in the environment. The importance of our study also lies in the fact that determining the minimum toxic concentration for these new synthetic compounds will be the basis for establishing the maximum concentration allowed in the environment.
According to our knowledge, data regarding the toxicity tests performed on heterotrophic bacteria cultures of the presented compounds cannot be found in the specialized literature.
Author Contributions
Conceptualization, M.E.R.-G., V.D.G. and S.P.; methodology, M.E.R.-G. and V.D.G.; software, V.D.G. and G.M.; validation, M.E.R.-G., V.D.G., S.P. and G.M.; formal analysis, M.E.R.-G., V.D.G., S.P. and G.M.; investigation, M.E.R.-G., V.D.G. and S.P.; resources, M.E.R.-G. and V.D.G.; data curation, M.E.R.-G., V.D.G., S.P. and G.M.; writing—original draft preparation, M.E.R.-G. and V.D.G.; writing—review and editing, M.E.R.-G., V.D.G., S.P. and G.M.; visualization, M.E.R.-G., V.D.G., S.P. and G.M.; supervision, M.E.R.-G. and V.D.G.; project administration, M.E.R.-G. and V.D.G.; funding acquisition, M.E.R.-G. and V.D.G. All authors have read and agreed to the published version of the manuscript.
Funding
Funded by the Romanian Ministry of Education and Research, CCDI—UEFISCDI (PN-IV-P8-8.3-PM-RO-BE-2024-0015).
Data Availability Statement
The original contributions presented in this study are included in the article. Further inquiries can be directed to the corresponding author.
Conflicts of Interest
The authors declare no conflicts of interest.
References
- Zollinger, H. Color Chemistry: Syntheses, Properties and Applications of Organic Dyes and Pigments, 3rd ed.; Wiley-VCH: Weinheim, Germany, 2003. [Google Scholar]
- Omar, A.Z.; Mohamed, M.G.; Homed, E.A.; El-Atavy, M.A. Characterization, DFT calculations and dyeing performance on polyester fabrics of some azo disperse dyes containing pyrazole ring. J. Saudi Chem. 2023, 27, 101594. [Google Scholar] [CrossRef]
- Matei, A.; Constantinescu, C.; Mitu, B.; Filipescu, M.; Ion, V.; Ionita, I.; Brajnicov, S.; Alloncle, A.P.; Delaporte, P.; Emandi, A.; et al. Laser printing of azoderivative thin films for non-linear optical applications. Appl. Surf. Sci. 2015, 336, 200–205. [Google Scholar] [CrossRef]
- Benkhaya, S.; M’rabet, S.; El Harfi, A. Classifications, properties, recent synthesis and applications of azo dyes. Helyion 2020, 6, e03271. [Google Scholar] [CrossRef]
- Yamjala, K.; Naiar, M.S.; Ramisetti, N.R. Methods for the analysis of azo dyes employed in food industry—A review. Food Chem. 2016, 192, 813–824. [Google Scholar] [CrossRef]
- Dembitsky, V.M.; Gloriozova, T.A.; Poroikov, V.V. Pharmacological and predicted activities of natural azo compounds. Nat. Prod. Bioprospecting 2017, 7, 151–169. [Google Scholar] [CrossRef]
- Hamidian, H. Synthesis of novel compounds as new potent tyrosinase inhibitors. Biomed. Res. Int. 2013, 2013, 207181. [Google Scholar] [CrossRef]
- Gupta, P.O.; Sekar, N. Investigation of heterocyclic azo dyes for dye-sensitized solar cells and non-linear optical properties: Synthesis and in-silico studies. J. Mol. Struct. 2025, 1321 Pt 4, 140035. [Google Scholar] [CrossRef]
- Nyaki, H.Y.; Mahmoodi, N.O. Investigation of solvatochromic, optical, organic field effect transistor (OFET), antibacterial, and molecular bonding of some azothiazolidine-2,4-dione -azo dyes. J. Photochem. Photobiol. A 2024, 450, 115475. [Google Scholar]
- Dandge, S.V.; NikuRme, S.R.; Bendre, R.S. An efficient synthesis, characterization, antimicrobial and anticancer activities of azo dyes derived from eugenol. Synth. Commun. 2024, 54, 282–292. [Google Scholar] [CrossRef]
- Jaiswal, A.; Kumari, N.; Kumar, A.; Prakash, R. Enhanced photodegradation of azo dye by Ag2O/SnO2@g-C3N4 nanocomposite. Mater. Chem. Phys. 2022, 281, 1258845. [Google Scholar] [CrossRef]
- Aragaw, T.A. Potential and prospects of reductases in azo dye degradation: A review. Microbe 2024, 4, 100162. [Google Scholar] [CrossRef]
- Brown, M.A.; de Vito, S.C. Predicting azo dyes toxicity. Crit. Rev. Environ. Sci. Tecnol. 1993, 23, 249–324. [Google Scholar] [CrossRef]
- Ansari, A. A review paper of benzidine. Int. J. Adv. Res. Sci. Commun. Technol. 2022, 2, 177–181. [Google Scholar] [CrossRef]
- Zweite Verordnung zur Änderung der Atomrechtlichen Verfahrensordnung, no. 82; Bundesgesetzblatt: Bonn, Germany, 1994.
- Vierte Verordnung zur Änderung der Bedarfsgegenständeverordnung, no. 8; Bundesgesetzblatt: Bonn, Germany, 1995.
- Bae, J.-S.; Freeman, H.S. Aquatic toxicity evaluation of new direct dyes to the Daphnia magna. Dye. Pigm. 2007, 73, 81–85. [Google Scholar] [CrossRef]
- Rizk, H.F.; El-Barai, M.A.; Ragab, A.; Ibrahim, S.A.; Sadek, M.E. A Novel of Azo-Thiazole Moiety Alternative for Benzidine-Based Pigments: Design, Synthesis, Characterization, Biological Evaluation, and Molecular Docking Study. Plycycl. Aromat. Comp. 2023, 43, 500–522. [Google Scholar] [CrossRef]
- Rădulescu-Grad, M.E.; Visa, A.; Milea, M.S.; Lazau, R.I.; Popa, S.; Funar-Timofei, S. Synthesis, spectral characterization, and theoretical investigations of a new azo-stilbene dye for acrylic resins. J. Mol. Struct. 2020, 1217, 128380. [Google Scholar] [CrossRef]
- Czajkovski, W. Sulphonated Diaminobenzanilides as Substitutes for Benzidine in the Synthesis of Direct Dyes. Dye. Pigm. 1991, 17, 297. [Google Scholar] [CrossRef]
- Simu, G.M.; Funar-Timofei, S.L.; Hora, S.G.; Schmidt, W.E.; Kurunczi, L.; Şişu, E.N.V.; Morin, N. Coloranţi Direcţi Derivaţi ai 4, 4′-Diaminobenzanilidei. I. Sinteza şi Studiul Izotermelor de Adsorbţie pe Bumbac ale unui Colorant Disazoic Direct cu Structură Asimetrică. Rev. Chim. 2002, 53, 826–829. [Google Scholar]
- Simu, G.M.; Hora, H.S.; Grad, M.E.; Şişu, E. Coloranţi direcţi derivaţi ai 4, 4′-diaminobenzanilidei. II. Sinteza şi evaluarea proprietăţilor tinctoriale a unor coloranţi disazoici cu structură asimetrică. Rev. Chim. 2004, 55, 873–878. [Google Scholar]
- Simu, G.M.; Chicu, S.A.; Morin, N.; Schmidt, W.; Şişu, E. Direct dyes derived from 4, 4′-diaminobenzanilide. Synthesis, characterisation and toxicity evaluation of a disazo symmetric direct dye. Turk. J. Chem. 2004, 28, 579–585. [Google Scholar]
- Simu, G.M.; Hora, S.G.; Grad, M.E.; Sisu, E.N. Direct dyes derived from 4, 4′-diaminobenzanilide. Synthesis, physicochemical properties and colouristic evaluation of some new trisazo direct dyes. Rev. Roum. Chim. 2005, 50, 113–117. [Google Scholar]
- Simu, G.M.; Muntean, S.G.; Grad, M.E.; Chicu, S.A.; Şişu, E. Coloranţi direcţi derivaţi ai 4, 4′-diaminobenzanilidei. III. Obţinerea, caracterizarea şi evaluarea toxicităţii unor noi coloranţi disazoici simetrici. Rev. Chim. 2006, 57, 1038–1040. [Google Scholar]
- Simu, G.M.; Agrigoroaie, G.; Dragomirescu, A.; Andoni, M. Synthesis, Physico-Chemical Characterisation and In Vivo Imagistic Skin Evaluation of a New Disazo Dye Containing Eco-Friendly Precursors. Rev. Chim. 2009, 60, 1309–1312. [Google Scholar]
- Simu, G.; Funar-Timofei, S.; Kurunczi, L.; Hora, S.; Schmidt, W.; Grad, M. Synthesis and Study of Adsorption Isotherms of a Trisazo Direct Dye on Cotton Fibre. Cellul. Chem. Technol. 2004, 38, 409–416. [Google Scholar]
- Simu, G.; Funar-Timofei, S.; Kurunczi, L.; Schmidt, W. A thermodynamic study of the sorption of an asymmetrical disazo direct dye on mercerized cotton. Rev. Roum. Chim. 2004, 49, 345–349. [Google Scholar]
- Simu, G.; Funar-Timofei, S.; Hora, S.; Kurunczi, L. Experimental and Theoretical Study of the Adsorption of a Trisazo Direct Dye Derived from 4, 4′-Diamino-benzanilide on a Cellulose Substrate. Molec. Cryst. Liq. Cryst. 2004, 416, 97–104. [Google Scholar] [CrossRef]
- Muntean, S.G.; Simu, G.M.; Sfarloaga, P.; Bologa, C. Study of a Trisazo Direct Dye Adsorption on Wood Fibre Using a Comparison of Different Adsorption Isotherms. Rev. Chim. 2010, 61, 70–73. [Google Scholar]
- Chicu, S.A. New insights into binary mixture toxicology: 2. Effects of reactive oxygen species generated by some carboxylic diesters on marine and freshwater organisms (VIII). Comput. Toxicol. 2023, 27, 100283. [Google Scholar] [CrossRef]
- Chicu, S.A.; Munteanu, M.; Cîtu, I.; Şoica, C.; Dehelean, C.; Trandafirescu, C.; Funar-Timofei, S.; Ionescu, D.; Simu, G.M. The Hydractinia echinata Test-System. III: Structure-Toxicity Relationship Study of Some Azo-, Azo-Anilide, and Diazonium Salt Derivatives. Molecules 2014, 19, 9798–9817. [Google Scholar] [CrossRef]
- Maglione, G.; Zinno, P.; Tropea, A.; Mussagy, C.U.; Dufossé, L.; Giuffrida, D.; Mondello, A. Microbes’ role in environmental pollution and remediation: A bioeconomy focus approach. AIMS Microbiol. 2024, 10, 723–755. [Google Scholar] [CrossRef] [PubMed]
- Frisbie, S.H.; Mitchell, E.; Abualrub, M.; Abosalem, Y.M. Calculating the Lowest Reportable Concentrations of Toxic Chemicals in the Environment. J. Appl. Math. Theor. Phys. 2015, 1, 9–13. [Google Scholar] [CrossRef]
- Jamee, R.; Siddique, R. Biodegradation of Synthetic Dyes of Textile Effluent by Microorganisms: An Environmentally and Economically Sustainable Approach. Eur. J. Microbiol. Immunol. 2019, 9, 114–118. [Google Scholar] [CrossRef] [PubMed]
- Pham, V.H.T.; Kim, J.; Chang, S.; Bang, D. Investigating Bio-Inspired Degradation of Toxic Dyes Using Potential Multi-Enzyme Producing Extremophiles. Microorganisms 2023, 11, 1273. [Google Scholar] [CrossRef] [PubMed]
Disclaimer/Publisher’s Note: The statements, opinions and data contained in all publications are solely those of the individual author(s) and contributor(s) and not of MDPI and/or the editor(s). MDPI and/or the editor(s) disclaim responsibility for any injury to people or property resulting from any ideas, methods, instructions or products referred to in the content. |
© 2025 by the authors. Licensee MDPI, Basel, Switzerland. This article is an open access article distributed under the terms and conditions of the Creative Commons Attribution (CC BY) license (https://creativecommons.org/licenses/by/4.0/).








